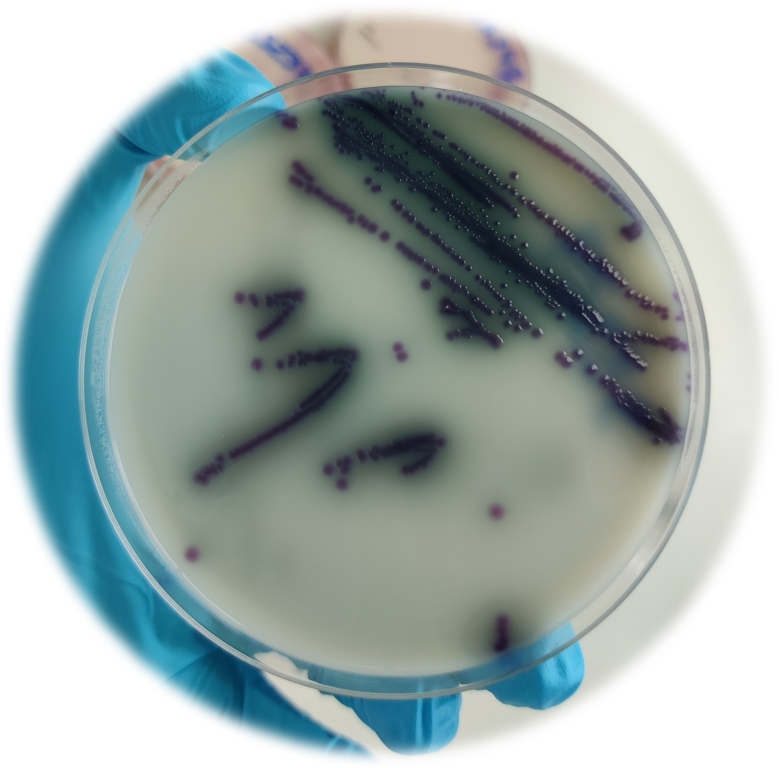
Dark blue/purple colour of Cevac® Salmovac colonies grown on ASAP media

Dark blue/purple colour of Cevac® Salmovac colonies grown on ASAP media
Ceva Launches Its ASAP™ Salmonella Differentiation Test
Ceva Animal Health is working with Biomerieux’s ASAP™ culture medium to provide assurance on how well birds have been vaccinated and as part of a standard laboratory method to differentiate its Cevac® Salmovac vaccine strain from field strains of Salmonella Enteritidis.
All laying flocks that adhere to the British Lion Code of Practice must be vaccinated against Salmonella Enteritidis and Salmonella Typhimurium during the rearing period. Environmental sampling is carried out to monitor the flocks for Salmonella infection from 22-26 weeks of age and continuing every 15 weeks throughout the laying period. Version 8 of the British Lion Code of Practice states that approved Salmonella testing laboratories must undertake testing to differentiate between field and vaccine strains of Salmonella.
Cevac Salmovac contains a double attenuated (adenine-histidine auxotrophic) Salmonella Enteritidis strain in live freeze-dried form which stimulates active immunisation in chickens, reducing colonisation, persistence, and invasion of the intestinal tract and internal organs by field strains of Salmonella Enteritidis and SalmonellaTyphimurium. It is administered via drinking water and pullets should be vaccinated with one dose from one day of age, a second dose six weeks later and a third dose around 13 weeks of age. Cevac Salmovac has the longest licensed duration of immunity of all the live Salmonella vaccines and is licensed to protect chickens for 63 weeks for Salmonella Enteritidis and 60 weeks for Salmonella Typhimurium following the third administration.
The Cevac Salmovac vaccine strain can occasionally be detected during routine sampling. When this occurs, the accredited laboratory can carry out the differentiation testing whilst also sending the samples to the official confirmatory laboratory for final identification.
The ISO 6579-2107 method describes the culture and identification of Salmonella from field samples after pre-enrichment on buffer peptone media. The bacterium is then cultured on MSRV media and a second media. ASAP is listed as one of the second media permitted by ISO 6579-2107 and significantly improves and speeds up the differentiation between vaccine and field strains, providing early reassurance to the producer that the official confirmation will identify the vaccine strain.
The ASAP Salmonella differentiation test has 100% sensitivity and 100% specificity for differentiating the Cevac Salmovac vaccine strain from any Salmonella field strain; Ceva Salmovac grows dark blue/purple colonies on ASAP media, while all other Salmonella bacteria field strains grow pink/red colonies.
“Several tests are available to differentiate Cevac Salmovac from Salmonella field strains, however using ASAP as a second medium significantly improves and speeds up the differentiation process, ensuring that laboratories can quickly and efficiently detect the presence of the Cevac Salmovac strain,” comments Pippa Abbey, poultry national veterinary services manager at Ceva Animal Health. “The ASAP media is also a useful tool for monitoring Cevac Salmovac drinking water vaccination and helps with vaccination auditing.”
Due to the vital importance of optimal administration of Salmonella vaccines, using ASAP media as a tool for monitoring the application can provide reassurance that the vaccine has been given successfully. On the day of vaccination, following priming of the drinker lines, a water sample can be taken from the end of the line and sent to the laboratory for testing. Cevac Salmovac will grow in dark blue/purple colonies indicating vaccine availability throughout the poultry house and a good vaccination process.
For further information on Ceva Salmovac, help with vaccination administration training or auditing, or the ASAP Salmonella differentiation test, please contact Ceva Animal Health on 01628 334056.
More from Ceva
- Why is my cat meowing so much? Feline behaviourist explains why cats become more vocal during spring
- Ceva hosts feline hypertension bitesize video series
- Vets and VNs urged to take blood pressure in cats
- Tick Season is starting: Simple Steps to Help Protect Pets This Spring
- Ceva supports Tiny the cat with StreetVet donation

 3 years ago
3 years ago  2366 views
2366 views
 5 days ago
5 days ago